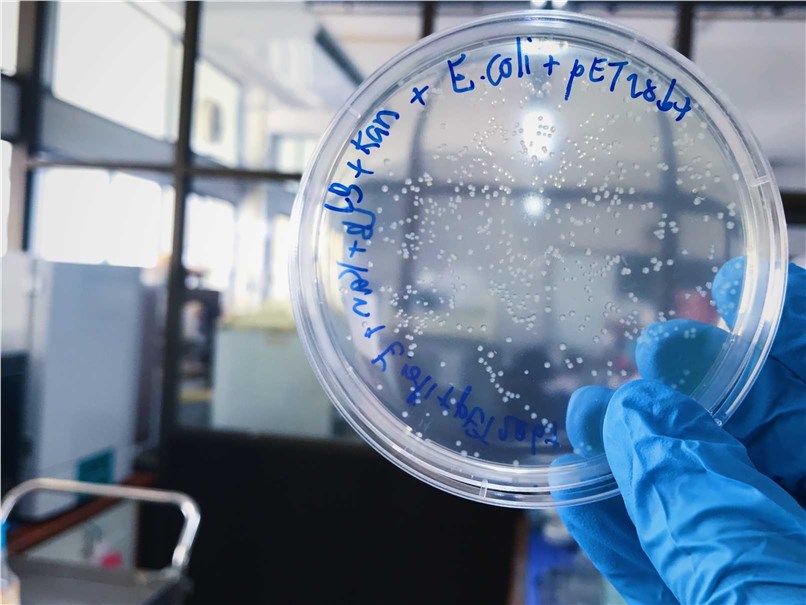
Plasmid Information

Structural Biology Tools
Inquiry
Creative Biostructure provides free tools related to structural biology, ranging from gene synthesis to structure determination. Here, you can use our tools to make your daily research easier.